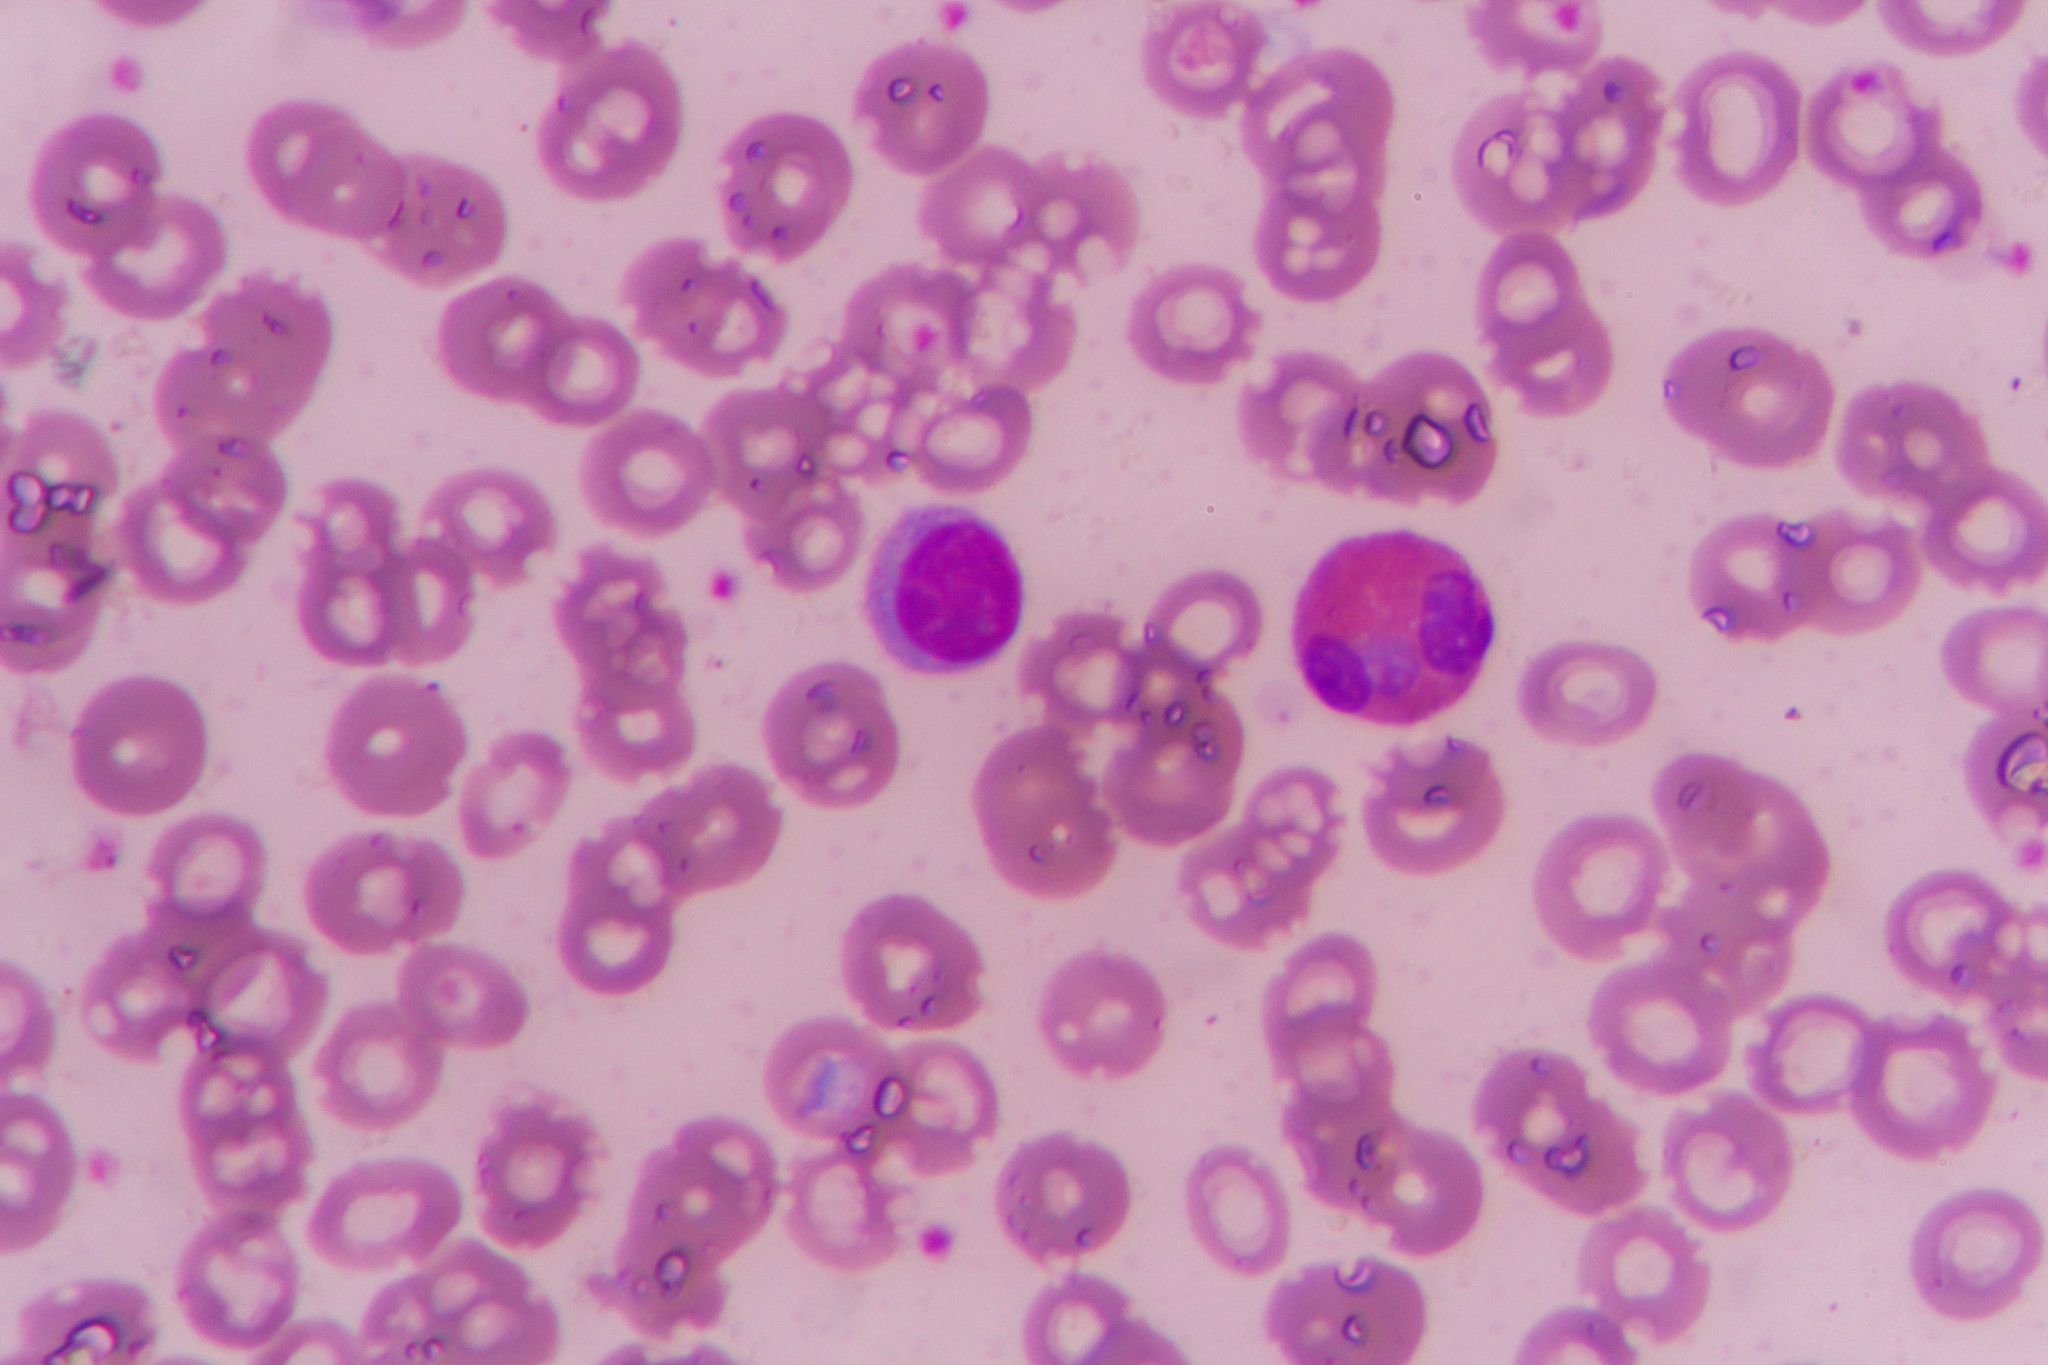
嗜碱性粒细胞白血病和肥大细胞白血病怎么鉴别诊断？

嗜碱性粒细胞白血病和肥大细胞白血病怎么鉴别诊断?
嗜碱性粒细胞白血病(HES)和肥大细胞白血病(MCL)在临床表现和实验室检查中有一些不同之处,可以通过以下方面进行鉴别诊断:
-
病因:HES多数是原发性病变,而MCL多为继发性病变。
-
血液学表现:HES患者血液中嗜酸性粒细胞数量正常或轻度升高,而MCL患者血液中肥大细胞数量明显增多。
-
组织学检查:HES患者骨髓中嗜碱性粒细胞克隆性增生,而MCL患者骨髓中肥大细胞明显增多,肥大细胞克隆性增生。
-
免疫分型:HES患者常表现为CD2、CD3、CD5、CD7、CD25、CD52、CD123等表面抗原阳性,而MCL患者常表现为CD2、CD25、CD117、CD123等表面抗原阳性。
-
临床表现:HES患者常表现为发热、皮肤瘙痒、肝脾肿大、淋巴结肿大等症状,而MCL患者常表现为皮肤瘙痒、皮肤红斑、荨麻疹、胃肠道症状等症状。
综上所述,通过对病因、血液学表现、组织学检查、免疫分型和临床表现的综合分析,可以较为准确地鉴别诊断嗜碱性粒细胞白血病和肥大细胞白血病。
原文地址: http://www.cveoy.top/t/topic/zvI 著作权归作者所有。请勿转载和采集!